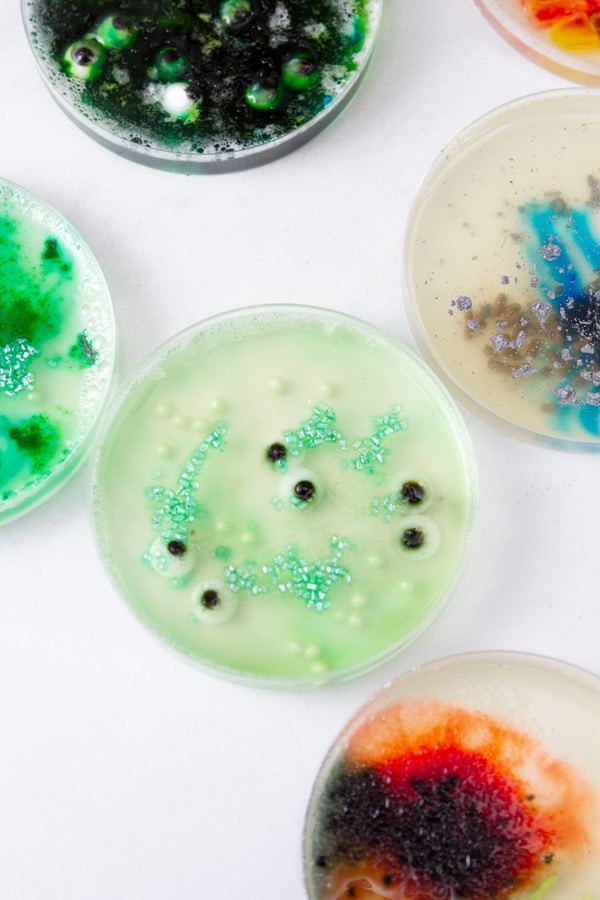
looking down into edible petri dishe gelatin with sprinkles and eyeballs.

This post may contain affiliate links. If you make a purchase through links on our site, we may earn a commission.
Petri Dish Treats are the perfect edible spooky science snacks for a fun and eerie Halloween party! These gelatin bites are quick, easy, and fun to make.
You could make these ahead of time for the party, or let guests and kids make their own. It’s a great kid-friendly Halloween project that doesn’t take any skill, even the littles will enjoy making their own science experiments!
Be sure to serve some Dark and Stormy cocktails or mocktails to sip on while you’re making these treats! And check out these Bandaid Cookies for more spooky treats!

We appreciate you
Please let me know if you have any questions about this recipe. I read all the comments myself and I try to help as soon as I can. I have readers from all levels of comfort and experience in the kitchen on my site, and I’ve tried to answer some of your questions already in the post. But if I’ve missed anything, please feel free to leave a comment and ask.
How to make creepy petri dish gelatin
First, you’ll want to grab all of your materials and get them set up.
Make sure you have the petri dishes. I ordered mine on Amazon. Grab yours with my affiliate link.
Each person decorating may want a rimmed baking dish or their own to help contain any spills or sprinkle explosions. Line the baking dish with parchment paper for added protection.
You can use so many things for the decorations! Go to the candy aisle at the store for inspiration.
Some starter ideas for the “bacteria” and add-ins: sprinkles, gummy worms, candy eyeballs, Nerds, Chewy Sweet Tarts, flower sprinkles (can look like organisms), food coloring, etc.

Make the gelatin
Next, start the gelatin.
Combine gelatin and water in a microwave safe bowl or measuring cup. I like the measuring cup because it has a pour spout which comes in handy later.
Microwave that in 15 second intervals until it’s melted. Now add the juice.
If you don’t have a microwave, you can heat the gelatin on the stove, it’ll just take longer.
Choose any flavor and color of juice that you like. I wanted mine to be lightly colored and slightly yellow so it looks like the agar medium that’s used in science.

I used pineapple-orange-guava juice. Apple juice, white grape juice, or even lemonade will work. Remember, your treats will taste like this juice when they are all done, so be sure you like the flavor.
You can even make an adult version and fill them up with some spirits. Just replace some of the juice with vodka for adult petri dish jello shots.
Divide the gelatin mixture between 14 petri dishes. The number of dishes may vary if yours are bigger or smaller than mine.
Fill them 3/4 of the way up, some of the decorations are going to take up space, adding to the volume in the petri dish.

Decorate them
Now the fun part! Decorate them.
Before the jelly has set, place candies, sprinkles, and food coloring in the petri dish. The drops of food coloring can look like mold. You can swirl the food coloring in a bit with a toothpick. The edges of the food coloring will probably feather a bit as the gelatin sets.
Transfer the dishes (this is another good reason to use the baking trays) to the fridge to chill and set for about an hour.
Your budget-friendly gelatin petri dishes are ready! Serve ‘em at your next mad-scientist or Halloween party! They also work for a science themed birthday party as a fun dessert.
My Halloween Brain is another great party idea!

Let’s keep in touch
If you like seeing my recipes subscribe via email in the upper right.
Or, connect with me on your favorite social media channel for recipes, photos, & much more:
Pinterest, Facebook, Instagram, YouTube and Twitter!
And find my shop on Amazon for recommendations on cool tools
If you try this recipe,
please come back & leave a comment below letting us know how it goes.
Share a picture & tag @lifecurrents on Instagram.
Or you can upload a “tried it” photo (I would love to see)
via the pin.

Petri Dish Recipe

Petri Dish Treats
Equipment
- microwave safe glass measuring cup
- Petri dishes
Ingredients
- 3 tablespoons powdered unflavored gelatin
- ¼ cup water
- 2 cups fruit juice
- candy and sprinkles
- food coloring
Instructions
- Combine the gelatin and water in a microwave safe glass measuring cup. Microwave in 15-second intervals until the gelatin has melted, stirring after each time.
- Mix the fruit juice into the gelatin, and whisk until well combined.
- Place the petri dishes on baking sheets to help move them and contain messes.
- Divide the gelatin juice evenly between 14 new clean petri dishes, filling about ¾ of the way full.
- Before the gelatin has set, place candies, sprinkles, and food coloring into the petri dishes. Use a toothpick to help swirl and place things.
- Transfer the decorated petri dishes to the fridge to set for about an hour.
Nutrition
Nutritional information is based on third-party calculations, and should be considered estimates. Actual nutritional content will vary based on brands used, measuring methods, portion sizes, and more.




Kathleen
Where were you when my kids were in school! I’m inviting my nephews kids over to make these for Halloween, 3 boys — they are going to LOVE them! We made them for a mad scientist party this weekend. They were a hit. Everyone loved them.
Jennifer
These are super cute!! We made some as a trial run for Halloween & they turned out perfectly!
Lynn
As a scientist by trade, I LOVE these!! I made them just to eat them & they were yummy fun. I used apple juice for my base.
Amy Nash
Bahaha these make me squirm in the best way! I LOVE these for our Halloween party this year!
Healing Tomato
This is a very creative idea! I have never thought of creating this spooky dish. Once, I would like to be at your halloween party!